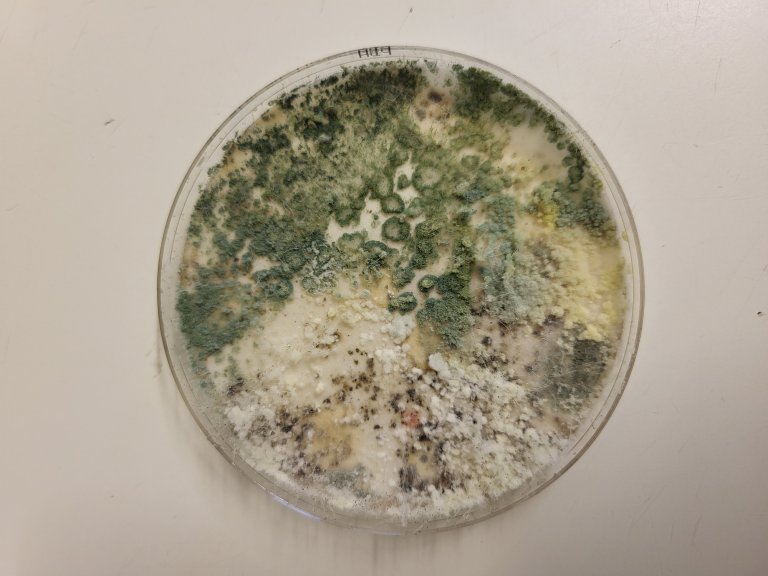
Soppvekst fra vannprøve. Noen av vannprøvene ble dyrket i laboratoriet, mens DNA fra andre prøver ble analysert med PCR og sekvenseringsteknologi. Foto: Dalphy Harteveld

Using metabarcoding to detect rot-causing fungi in apples

Many types of fungi can cause rot in apples, both before and after harvest. Photo: Jorunn Børve
Rot development during fruit storage is a problem. Now, metabarcoding may become a tool for detecting fungi that can cause diseases in apples.
Many types of fungi can cause rot in apples, both before and after harvest. In packing facilities, apples are often sorted in water, but researchers do not yet know whether fungal spores from rotten apples can spread through the water and infect healthy ones.
At NIBIO, researchers are using modern technology to study the sorting water. Metabarcoding is a DNA-based method that makes it possible to identify many microorganisms simultaneously—without having to culture them in a laboratory.

Lying latent
“Many fungi cause diseases during storage. The apples are harvested looking nice and healthy, but after two or three months in storage, rot spots appear. This leads to food waste because the apples have to be discarded,” says NIBIO researcher Dalphy O. C. Harteveld.
Often, the fungi are already present on the apples while they’re still in the orchard. They exist in and on the surface of the fruit without showing symptoms but break out later during storage, she explains.
When the apples are sorted, the harvest bin is gently emptied into water before being transported through water channels for size and colour sorting. Rotten apples are removed first—ideally before size and colour sorting.
“We get questions from fruit storage facilities about whether these fungi can be present in the transport water, in the machines, and on the sorting lines. That’s why we examined the water to see if we could find the same fungal species that cause rot,” says Harteveld.
DNA as a tool
Researchers at NIBIO use metabarcoding. The method involves extracting DNA from samples of water, soil, or plant tissue and amplifying specific parts of the genetic material that act as ‘barcodes’ for different organisms. These DNA sequences are then compared with databases to identify which fungi and bacteria are present.
“Metabarcoding allows us to see the entire microbial community in a sample, not just the species that can be cultured,” Harteveld explains.
“It’s really about how we can use artificial intelligence and DNA technology in plant pathology.”
.jpg)
From field to storage
“We followed the apples from the field, recorded which diseases they had at harvest and after storage, and examined whether there was a connection between fruit rot and the fungi we found in the water,” Harteveld says.
Some of the water samples were cultured in the lab, while DNA from other samples was analysed using PCR and sequencing technology. This allowed researchers to compare which fungal species grew in culture and which could also be detected in the water.
Promising results
The results suggest that the method works well.
“We see that metabarcoding can detect fungal species in the water that are otherwise difficult to culture. It gives us a much more complete picture of the microorganisms,” says Harteveld.
She explains that the method cannot yet identify all organisms down to species level but provides an important starting point for further investigation of specific species.
“There are many bacterial and fungal species in the samples, and they influence each other. This project is a first step to determine whether we can detect multiple fungi that cause fruit rot simultaneously—and it looks like we can identify the relevant ones,” she says.

Looking at connections
The researchers are now working to understand how the microbial community affects the development of symptoms.
“When we look at the apples, we don’t always find a direct link between the water and the rot. The fungus may already be on the peel from the field. We’re now comparing the apple peel of two varieties at harvest and after storage to see whether the microbes differ between healthy apples and those that develop rot,” Harteveld explains.
Another part of the research involves bioinformatics—analysing the large amounts of DNA data from metabarcoding.
“To make sense of all this, we’re updating an analysis tool where an AI assistant helps us interpret the results. That’s going to be very useful,” she says.
“We’re also part of another project using metabarcoding to assess the health of cucumbers grown in hydroponic systems. There, researchers are studying how water quality and bio stimulants affect both plant health and microbial communities over time,” she adds.
Developing the method further
The researchers’ goal is to further develop metabarcoding into a precise tool for detecting infections by multiple fungi that cause diseases in apples simultaneously, and to study how they are influenced by factors such as microbial communities, climate change, and plant protection practices.
“We’ve had to build up the methodology for the fungal species relevant to apples. It’s crucial that we understand the technology and use it correctly—only then can we fully realize its potential,” Harteveld concludes.
Contacts

Dalphy Ondine Camira Harteveld
Research Scientist
-
Division of Biotechnology and Plant Health
(+47) 980 94 257 dalphy.harteveld@nibio.no Office Location: Ås H7
Metabarcoding
Metabarcoding is a DNA-based method for identifying many species simultaneously by analyzing a mixture of DNA barcodes (genetic “ID tags”) from all the organisms in the sample.


Contacts

Dalphy Ondine Camira Harteveld
Research Scientist
-
Division of Biotechnology and Plant Health
(+47) 980 94 257 dalphy.harteveld@nibio.no Office Location: Ås H7




